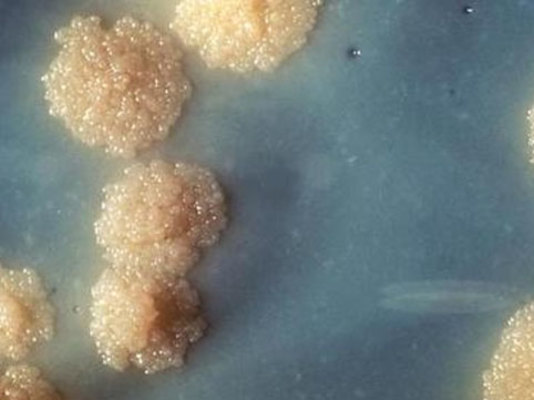
Vərəmdən qorunmağın yolları və

Əhali arasında öskürək, təngnəfəslik, tənəffüslə bağlı müxtəlif narahatlıqlar izlənməkdədir. Bu əlamətlər hansı xəstəliklərin göstəricisi ola bilər?
7News.az bildirir ki, bu barədə sualları Azərbaycan Tibb Universitetinin Ağciyər xəstəlikləri kafedrasının müdiri, tibb üzrə fəlsəfə doktoru, dosent Rafiq İdris oğlu Bayramov cavablandırıb.
-Vərəm xəstəliyinin əlamətləri nədir?
- Bütün xəstəliklərdə olduğu kimi vərəm xəstəliyinin də mütləq patoqnomik əlaməti yoxdur. Yəni elə bir əlamət yoxdur ki, ona görə biz əminliklə müayinə etdiyimiz şəxsdə vərəm xəstəliyinin olduğunu söyləyək. Ancaq vərəm xəstəliyində daha çox rast gəlinən əlamətlər, ümumi halsızlıq, axşamüstü zəif subfebril hərarətin (37,2-37,4) olması və səhərə yaxın boyun-ənsə, kürək nahiyyəsinin tərləməsidir. Bu əlamətlərin olmasına görə hər hansı bir orqanın vərəm xəstəliyindən şübhələnmək olar. Amma diaqnozun təsdiqi üçün kompleks müayinənin aparılması lazımdır.
-Müəyyən bir insan əlamətlərinə görə vərəm xəstəsi olduğundan xəbər tuta bilərmi ya bu ancaq laborator muayinələr zamanı aşkarlanır?
- Əvvəlcə də söylədiyim kimi, əlamətlərə görə vərəm xəstəliyindən yalnız şübhələnmək olar. Yəni, vərəmin daha çox rast gəlinən forması olan tənəffüs orqanlarının, ağciyərlərin vərəmi zamanı yuxarıda söylədiyim əlamətlərlə yanaşı bəlğəmli öskürək, döş qəfəsində ağrı, təngnəfəslik, qanhayxırma və s. müşahidə olunur. Dəqiq diaqnozun qoyulması üçün isə xəstənin tam müayinəsi vacibdir.
-Doğrudurmu ki, güclü immunitetə malik olan insanlar vərəm xəstəliyinə tutula bilməz?
-Çox yerinə düşən bir deyim var ki, vərəm elə xəstəlikdir ki, heç vaxt öz vizit kartını əvvəlcədən heç kəsə göndərmir. Bu baxımdan hər bir kəs ömrünün istənilən dövründə vərəmlə xəstələnə bilər. Ancaq təbii ki, vərəmlə xəstələnməyə görə risk qrupu olan şəxslər var ki, o, insanlarda vərəm daha çox rast gəlinir. Bu risk qrupunu təşkil edən insanlarda immunitetin zəifləməsi əsas faktorlardan biridir. Qeyd etmək istəyirəm ki, normal həyat tərzi keçirən, zərərli vərdişləri və vərəmə meylliliyi artıran yanaşı xəstəlikləri (məs. şəkərli diabet, hormonal preparatların qəbulu) olmayan, həmçinin irsi olaraq bu xəstəliyə davamlı olan şəxslər vərəmlə çox az-az hallarda xəstələnir.
- Bu mövzuda işlərkən "viraj" termininə rast gəldim. Anlamı nədir?
- Viraj, vərəmə görə profilaktik müayinədə və vərəmin diaqnostikasında istifadə olunan tuberkulin sınağının (Mantu sınağı) ilk dəfə müsbət olmasıdır. Yəni uşaqlarda hər il istifadə olunan Mantu sınağı mənfi olub, növbəti dəfə müsbət olarsa bu tuberkulin sınağının virajı adlanır. Viraj hərfi mənada döngə, geriyə dönmə demək olub, sağlamlıqdan xəstəliyə dönmə anlamı verir və vərəm infeksiyasına yoluxmanı göstərir. Ona görə də viraj olan uşaqlar vərəmə görə kompleks müayinə olunmalıdır.
- Cəmiyyətimizdə bir vərəm qorxusu var, yəni hansısa ailədə vərəm xəstəsinin olması üzə çıxarsa, o zaman bundan məlumatlı olan ətrafdakılar o ailə ilə ünsiyyətdən qaçırlar. Buna görə də çox vaxt bu xəstəliyə yoluxanlar gizlətməyə çalışır, bu xəstəliyin daşıyıcısı olduğunu etiraf etməkdən utanırlar.. Çünki xəstə insanlar öz xəstəliklərinin başqa adla - keçici olmayan xəstəlik kimi təqdim etməklə qarşı tərəfin ona yoluxma riskini artırırlar. Bu haqda qısaca...
- Bəli, cəmiyyətdə vərəm xəstəliyinə münasibətin birmənalı və müsbət olmaması vərəmə tutulan şəxslərin əksər hallarda öz xəstəliyini gizlətməyə çalışmasına səbəb olur. Burada bir səbəb də, cəmiyyətdə vərəmlə qeyri-normal, o cümlədən tüfeyli həyat tərzi keçirən şəxslərin, alkoqoliklərin, narkomanların, həsxanada olanların xəstələnməsi fikrinin olmasıdır. Düzdür bu insanlarda vərəm daha çox rast gəlinir. Ancaq tam normal həyat tərzi və yaşayış şəraiti olan şəxslər də vərəmlə xəstələnə bilər. Buna görə də, cəmiyyətdə bu məsələ ilə bağlı maarifləndirmə tədbirlərinin artırılması yaxşı olardı. Onu da qeyd edim ki, vərəm tam sağalan xəstəlikdir. Sadəcə xəstəlik nə qədər erkən aşkar olunub düzgün müalicə olunarsa daha effektli olar. Vərəmlə xəstələnənlər vaxtında aşkar olunub kompleks müalicə olunmalı, bu xəstələrlə təmasda olanlar isə profilaktik müayinə və müalicə kursu qəbul etməlidirlər.
-Quru öskürək və bəlğəmli öskürək bunların müalicə üsulları da müxtəlifdirmi? Yəni öskürəyin növünü araşdırmadan aptekden hər hansı bir öskürəyə qarşı dərman alıb içmək nə dərəcədə düzgün sayıla bilər?
-Həm quru, həm də bəlğəmli öskürək tənəffüs orqanlarının müxtəlif xəstəliklərinin əlamətləridir. Bu xəstələrin müalicəsində müxtəlif dərman preparatlarından istifadə edilir. Quru öskürəkdə öskürək əleyhinə preparatlar, bəlğəmli öskürəkdə isə bəlğəmgətiricilər daha effektlidir. Buna görə də özünümüalicə ilə məşğul olmaq və aptekdən həkim təyinatı olmadan öskürək əleyhinə preparatın alınıb qəbul edilməsi düzgün deyil. Çünki, bəlğəmli öskürəkdə yalnız öskürək əleyhinə preparartların istifadə edilməsi öskürəyin dayanmasına və nəticədə tənəffüs yollarındakı bəlğəmin xaric edilməməsi nəticəsində xəstənin vəziyyətinin daha da pisləşməsinə səbəb olar. Onu da qeyd etmək lazımdır ki, öskürək əlamətdir. Ona səbəb olan əsas xəstəliyin aşkar olunub, müalicə edilməsi lazımdır.
-Xalq arasında çox populyar olan turpu ovub içinə bal töküb suyunu içmək kimi bir mualicə doğrudanmı öskürəyin qarşısını ala bilər?
-Öskürəyin aradan qaldırılması üçün çoxsaylı kimyəvi preparatlar və türkəçarə üsulları var. Söylədiyiniz türkəçarə metodunun da xeyri var. Ancaq yenə təkrar edim ki, öskürək tənəffüs orqanlarının xəstəliklərinin əlamətlərindən biridir. Ona görə də öskürəyin səbəbini araşdırıb, əsas xəstəliyi kompleks müalicə etmək daha effektli olar./saqlamhəyat.az
7News.az